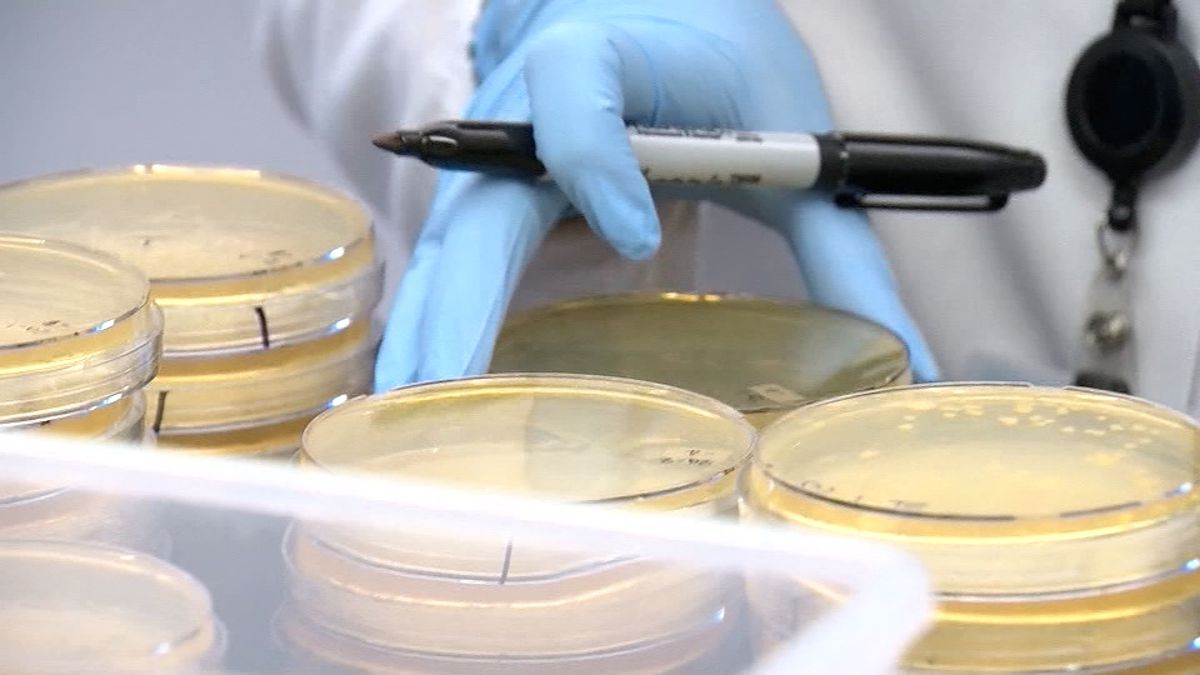

Coronaviruses Timeline
 Timeline How The New Coronavirus Spread China News Al Jazeera
Timeline How The New Coronavirus Spread China News Al Jazeera

 Timeline How The New Coronavirus Spread China News Al Jazeera
Timeline How The New Coronavirus Spread China News Al Jazeera
 A Novel Coronavirus Capable Of Lethal Human Infections An
A Novel Coronavirus Capable Of Lethal Human Infections An
 Figure Timeline Of Disease Of Novel Coronavirus Case And Possible
Figure Timeline Of Disease Of Novel Coronavirus Case And Possible
 Viruses Free Full Text Return Of The Coronavirus 2019 Ncov
Viruses Free Full Text Return Of The Coronavirus 2019 Ncov
 Coronavirus Intermountain Healthcare
Coronavirus Intermountain Healthcare
 Coronavirus Vs Flu How Do They Compare World Economic Forum
Coronavirus Vs Flu How Do They Compare World Economic Forum
 How The New Coronavirus Stacks Up Against Sars And Mers Science News
How The New Coronavirus Stacks Up Against Sars And Mers Science News
 Coronavirus Everything You Need To Know World Breakings News
Coronavirus Everything You Need To Know World Breakings News
 Figure Timeline Of Possible Exposure And Clinical Course Of Middle
Figure Timeline Of Possible Exposure And Clinical Course Of Middle
 How The New Coronavirus Stacks Up Against Sars And Mers Science News
How The New Coronavirus Stacks Up Against Sars And Mers Science News
Who Emro Emerging Respiratory And Novel Coronavirus 2012
 Timeline Of Three Novel Coronavirus Cases United Kingdom
Timeline Of Three Novel Coronavirus Cases United Kingdom
 Wuhan Coronavirus Timeline Youtube
Wuhan Coronavirus Timeline Youtube
Novel Coronavirus 2019 Response Jan 15 21 Snohomish Health
 Coronavirus Timeline Thursday March 5
Coronavirus Timeline Thursday March 5
 Timeline Of Exposures Symptom Onset And Diagnosis Of Middle East
Timeline Of Exposures Symptom Onset And Diagnosis Of Middle East
No Further Evidence Of Novel Coronavirus
 Timeline Health Department County Leaders To Discuss Presumptive
Timeline Health Department County Leaders To Discuss Presumptive
 Timeline How The New Coronavirus Spread China News Al Jazeera
Timeline How The New Coronavirus Spread China News Al Jazeera
 Coronavirus A Timeline Of How The Deadly Outbreak Is Evolving
Coronavirus A Timeline Of How The Deadly Outbreak Is Evolving
/arc-anglerfish-arc2-prod-expressandstar-mna.s3.amazonaws.com/public/CM6EQJQXA5HBVF7INGUNIYPXLE.jpg) Coronavirus Timeline Of Confirmed Cases In The Uk Express Star
Coronavirus Timeline Of Confirmed Cases In The Uk Express Star
 Coronavirus Outbreak A New Mapping Tool That Lets You Scroll
Coronavirus Outbreak A New Mapping Tool That Lets You Scroll
 A Timeline Of The Coronavirus The New York Times
A Timeline Of The Coronavirus The New York Times
 Scott Gottlieb Md On Twitter Novel Wuhan Coronavirus Timeline
Scott Gottlieb Md On Twitter Novel Wuhan Coronavirus Timeline
This Is The Timeline Of When And How The Metro Coronavirus
This Is The Timeline Of When And How The Metro Coronavirus
 Coronavirus Arrives In The Us How Worried Should You Be Observer
Coronavirus Arrives In The Us How Worried Should You Be Observer
 Figure Middle East Respiratory Syndrome Coronavirus During
Figure Middle East Respiratory Syndrome Coronavirus During
 Coronavirus Timeline How Has The Virus Spread Bt
Coronavirus Timeline How Has The Virus Spread Bt
 Timeline How Coronavirus Got Started Abc News
Timeline How Coronavirus Got Started Abc News
 Timeline Tracking The Spread Of Covid 19 In Tri State Nbc New York
Timeline Tracking The Spread Of Covid 19 In Tri State Nbc New York
 Updated Timeline Of The Coronavirus Think Global Health
Updated Timeline Of The Coronavirus Think Global Health
 As Coronavirus Spreads Vendors Of Supply Risk Management Share
As Coronavirus Spreads Vendors Of Supply Risk Management Share
 Timeline How Trump Was Out Of Step With The Cdc During
Timeline How Trump Was Out Of Step With The Cdc During
 Coronavirus Clouds Apple S Timeline For New Iphones The Star Online
Coronavirus Clouds Apple S Timeline For New Iphones The Star Online
 Coronavirus Timeline From Wuhan To Washington State World News
Coronavirus Timeline From Wuhan To Washington State World News
 Coronavirus Sars Cov 2 Timeline And Updates Collaborative
Coronavirus Sars Cov 2 Timeline And Updates Collaborative
 San Antonio Loses Court Fight To Extend Quarantine For Coronavirus
San Antonio Loses Court Fight To Extend Quarantine For Coronavirus
 Coronavirus Everything You Need To Know World Breakings News
Coronavirus Everything You Need To Know World Breakings News
 Coronavirus Update Information About The Outbreak Of Covid 19 And
Coronavirus Update Information About The Outbreak Of Covid 19 And
 Google Search Results For Coronavirus Includes Sos Alert Info
Google Search Results For Coronavirus Includes Sos Alert Info
 Evidence For Camel To Human Transmission Of Mers Coronavirus Nejm
Evidence For Camel To Human Transmission Of Mers Coronavirus Nejm
Vaccine For Wuhan China Coronavirus Timeline Development
 Latest On Coronavirus Timeline Of Events Since The Start Of The
Latest On Coronavirus Timeline Of Events Since The Start Of The
 What We Know About Singapore S First Locally Transmitted
What We Know About Singapore S First Locally Transmitted
 Will Coronavirus Continue Its Silent Sometimes Deadly March What
Will Coronavirus Continue Its Silent Sometimes Deadly March What

 How Bad Is Coronavirus Versus The Flu And Ebola
How Bad Is Coronavirus Versus The Flu And Ebola
Epidemiological Data From The Ncov 2019 Outbreak Early
Coronavirus China S Lightning Response May Not Be Enough
 Coronavirus Nc State Of Emergency Declared In North Carolina As
Coronavirus Nc State Of Emergency Declared In North Carolina As
 Timeline How Australia Responded To The Coronavirus Outbreak
Timeline How Australia Responded To The Coronavirus Outbreak
 Coronavirus Vaccine Faces Bumpy Road From Lab To Jab Voice Of
Coronavirus Vaccine Faces Bumpy Road From Lab To Jab Voice Of
 What We Know About The New Novel Coronavirus A Timeline Public
What We Know About The New Novel Coronavirus A Timeline Public
 How Bad Will The Coronavirus Outbreak Get Here Are 6 Key Factors
How Bad Will The Coronavirus Outbreak Get Here Are 6 Key Factors
 Coronavirus Clouds Apple S Timeline For New Iphones Business
Coronavirus Clouds Apple S Timeline For New Iphones Business
 Timeline Coronavirus Around The World Cgtn
Timeline Coronavirus Around The World Cgtn
 Wuhan S Coronavirus Outbreak Life Inside The Quarantine
Wuhan S Coronavirus Outbreak Life Inside The Quarantine
 Figure Community Transmission Of Severe Acute Respiratory
Figure Community Transmission Of Severe Acute Respiratory

![]() Coronavirus Outbreak Timeline Fast Facts Ktvz
Coronavirus Outbreak Timeline Fast Facts Ktvz

 Coronavirus In Canada Here S A Timeline Of Cases Across Provinces
Coronavirus In Canada Here S A Timeline Of Cases Across Provinces
 Timeline Of How New Coronavirus Has Spread East Asia News Top
Timeline Of How New Coronavirus Has Spread East Asia News Top
 Coronavirus Timeline Freightwaves
Coronavirus Timeline Freightwaves
 Figure 2 Timeline Of Coronavirus Emergence Events
Figure 2 Timeline Of Coronavirus Emergence Events

 Novel Coronavirus Latest Timeline Of Covid 19 Cases In Canada
Novel Coronavirus Latest Timeline Of Covid 19 Cases In Canada
 Timeline Where Did Wake County S Newest Covid 19 Patients Go And
Timeline Where Did Wake County S Newest Covid 19 Patients Go And
 Coronavirus Outbreak Timeline Fast Facts Kion546
Coronavirus Outbreak Timeline Fast Facts Kion546












:strip_exif(true):strip_icc(true):no_upscale(true):quality(65)/arc-anglerfish-arc2-prod-gmg.s3.amazonaws.com/public/HFLYYFXSX5FYXC7JILYSPS2E3A.jpg)











:strip_exif(true):strip_icc(true):no_upscale(true):quality(65)/arc-anglerfish-arc2-prod-gmg.s3.amazonaws.com/public/DDKVWRK365B5BDUMPSTCWT2VYE.jpg)


0 Comments
Posting Komentar